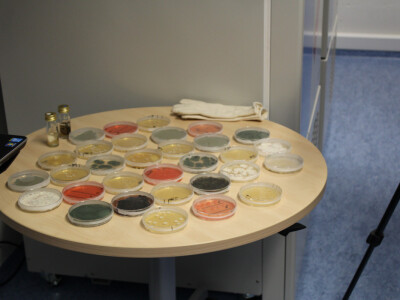
Snažan rast BASF-ovog sektora Zaštite bilja!

Pretraživanje foto priloga
- KLUB, društvena mreža
- Zadnje aktivnosti
- Poslednje aktivnosti korisnika mogu videti samo registrovani korisnici.
- Online korisnici
- Online korisnike Agrokluba mogu videti samo registrovani korisnici.
- Za kompletne funkcionalnosti ovih servisa, prijavi se.